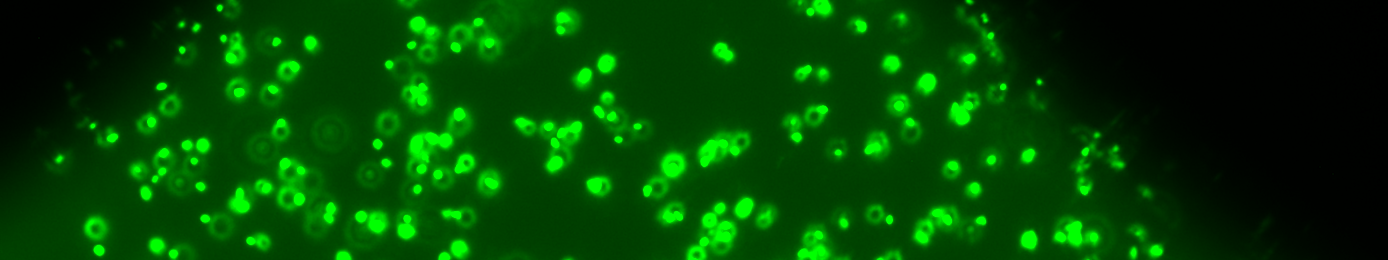

Makro-Skala-Modellierungskonzepte
für das Wachstum und den advektiven Transport von Bakterien in mit zwei Phasen gesättigten porösen Medien
Laufzeit
01.10.2019 - 30.09.2022
Leitung
Beschreibung
Poröse Medien bieten exzellente Lebensbedingungen für Bakterien, da ihr Lebensraum geschützt ist aber trotzdem eine kontinuierliche Nahrungezufuhr möglich ist. Folglich existieren Mikroorgansimen in vielen natürlichen und technischen porösen Medien und haben dort einen großen Einfluss. Wenn diese für technische oder industrielle Anwendungen genutzt werden, ist es sehr wichtig die Wechselwirkungen zwischen Strömung, Transport und mikrobiologischen Prozessen zu verstehen. In der Literatur ist eine Vielzahl von Modellierungsmethoden vorhanden, jedoch sind diese in der Regel unter einphasigen Strömungsbedingungen entwickelt worden. Es ist schwierig mikrobiologische Prozesse in den natürlichen und komplexen Porenstrukturen von Gesteinen (wie z.B. Anhaften/Ablösen und Bildung von Biofilmen) zu beobachten und demzufolge sind diese Prozesse unzureichend erforscht.
In diesem Projekt werden künstliche Strukturen geschaffen, die den Porenstrukturen des Gesteins nachempfunden sind und dafür benutzt, das Verhalten von Bakterien in mit zwei Phasen gesättigten porösen Medien zu untersuchen. Diese transparenten sozusagen zweidimensionalen Mikromodelle erlauben eine direkte Beobachtung der mikrobiologischen Prozesse, wie z.B. Wachstum, Transport und Anhaftung/Ablösung von Bakterien, durch mikroskopische Auswertungen. Die Bakterien, die für die experimentellen Untersuchungen eingesetzt werden, gehören zu der Klasse der methanogenen Archaeen. Die detaillierte Interpretation der experimentellen Ergebnisse durch Bilddatenverarbeitung erlaubt es, zeitlich und räumlich aufgelöste Datensätze für die Anzahl, Struktur und Bewegung der Bakterien zu erzeugen. Aus diesen Datensätzen wird ein verbessertes mathematisches Modell entwickelt, welches das Wachstum und die Bewegung von Bakterien in mit zwei Phasen gesättigten porösen Medien beschreibt. Das Modell soll das bakterielle Wachstum unter nicht-nährstofflimitierten Bedingungen, das Vorhandensein von verschiedenen bakteriellen Strukturen (Plankton und Biofilm), die individuellen Bewegungseigenschaften und die Anhaftungs- und Ablösevorgänge berücksichtigen. Um das neu entwickelte Modell zu testen und zu parametrisieren, wird es auf Basis eines diagonal-impliziten Runge-Kutta-Verfahrens, welches für die stark nicht-linearen Quellterme gut geeignet ist, numerisch umgesetzt.
Die Anwendung des theoretischen Modells bezieht sich auf die Technologie der Untergrundmethanisierung, in welcher das injizierte Gasgemisch aus Wasserstoff und Kohlenstoffdioxid durch mikrobiologische Reaktionen in Methan umgewandelt wird.
Kontakt
Sponsoren und Partner
Dieses Projekt wird durch die Deutsche Forschungsgemeinschaft (DFG) gefördert.